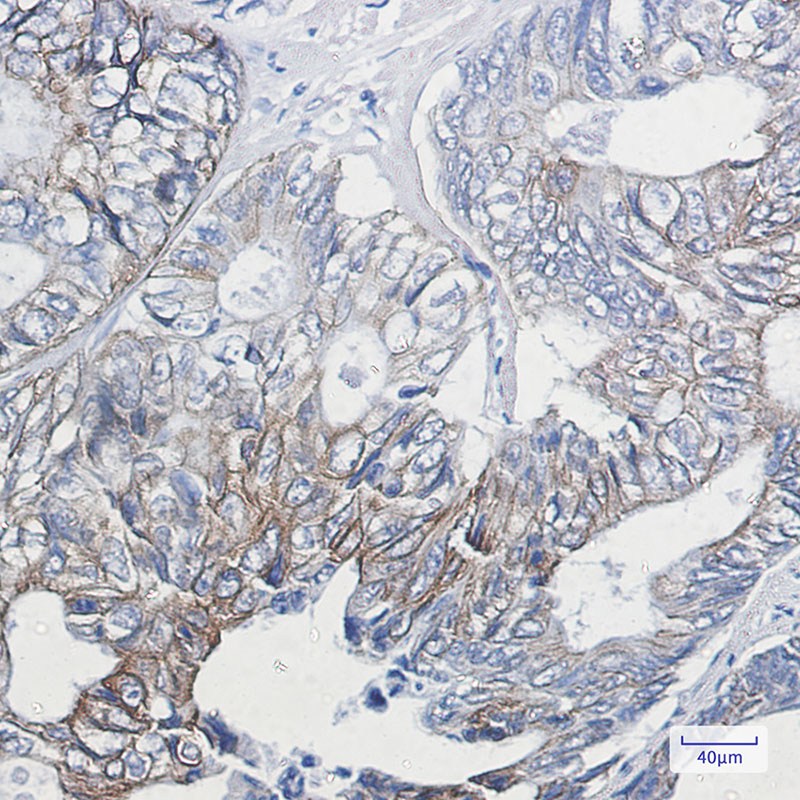

-
分类: 科研抗体货号: P20102别名: GRIA1; GLUH1; GLUR1; Glutamate receptor 1; GluR-1; AMPA-selective glutamate receptor 1; GluR-A; GluR-K1; Glutamate receptor ionotropic; AMPA 1; GluA1应用: WB反应种属: Human,Rat
-
分类: 科研抗体货号: P20113别名: KRT8; CYK8; Keratin; type II cytoskeletal 8; Cytokeratin-8; CK-8; Keratin-8; K8; Type-II keratin Kb8应用: WB,IP,IHC,IF反应种属: Human
-
分类: 科研抗体货号: P20089别名: GSK3B; Glycogen synthase kinase-3 beta; GSK-3 beta; Serine/threonine-protein kinase GSK3B应用: WB,IHC,IF反应种属: Human,Mouse,Rat
-
分类: 科研抗体货号: P20101别名: ACACA; ACAC; ACC1; ACCA; Acetyl-CoA carboxylase 1; ACC1; ACC-alpha应用: WB反应种属: Human
-
分类: 科研抗体货号: P20112别名: MYC; BHLHE39; Myc proto-oncogene protein; Class E basic helix-loop-helix protein 39; bHLHe39; Proto-oncogene c-Myc; Transcription factor p64应用: WB,IP,IF反应种属: Mouse,Rat
-
分类: 科研抗体货号: P20088别名: RPS6KA1; MAPKAPK1A; RSK1; Ribosomal protein S6 kinase alpha-1; S6K-alpha-1; 90 kDa ribosomal protein S6 kinase 1; p90-RSK 1; p90RSK1; p90S6K; MAP kinase-activated protein kinase 1a; MAPK-activated protein kinase 1a; MAPKAP kinase 1a; MAPKAP应用: WB,IP反应种属: Human,Mouse,Rat
-
分类: 科研抗体货号: P20138别名: PLN; PLB; Cardiac phospholamban; PLB应用: WB反应种属: Human,Mouse
-
分类: 科研抗体货号: P20111别名: CDC2; CDC28A; P34CDC2应用: WB,IP反应种属: Human,Hamster
-
分类: 科研抗体货号: P20087别名: CBL; CBL2; RNF55; E3 ubiquitin-protein ligase CBL; Casitas B-lineage lymphoma proto-oncogene; Proto-oncogene c-Cbl; RING finger protein 55; Signal transduction protein CBL应用: WB,IP反应种属: Human,Rat
-
分类: 科研抗体货号: P20137别名: MXRA2; CH-ILKBP应用: WB,IF反应种属: Human,Mouse,Rat

鄂公网安备42018502007531号
鄂公网安备42018502007531号

